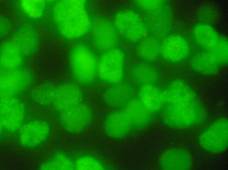

|
Home  Team Team  Contact us Contact us |
| About us | Our activity | Highlights | Publications | Gallery | New events |
| RE-doped nanocrystals | J-aggregates | Cell marking | Inorganic synthesis | Organic synthesis |
 |
 |
 |
Cell marking and estimation of transmembrane potentials
Our group deals with marking of single cells and transmembrane potential estimation in single hepatocytes based on using voltage-sensitive probes. This method can be used in real-time research of different factor influences on cells functional state.
Single cells marked with different dyes (DiO, DiD, Sq and JC-1, respectively):


Rat hepatocyte cells marked with RE-doped inorganic nanoparticles:
The lipoprotein complex containing activated hydroxyapatite nanoparticles on a plasma membrane surface of hepatocyte cells of rat.
Hepatocyte cell of rat: a) transmitted light image b) luminescent image of the same cell incubated with modified ReVO4:Eu3+ nanocrystals, that interacting only with membrane of cell nucleus
to the top